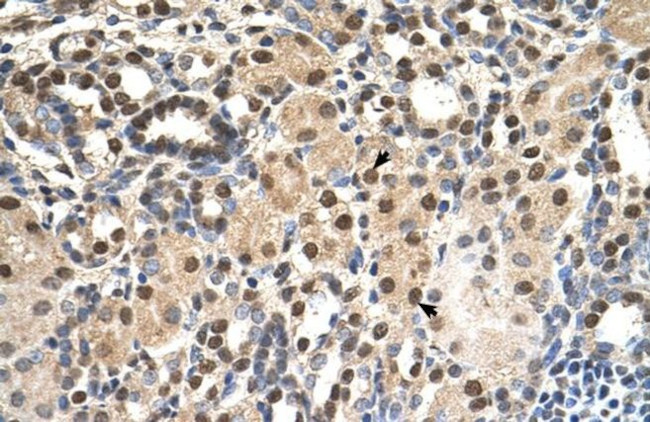
PHAP III Antibody in Immunohistochemistry (IHC)

Search
Invitrogen
PHAP III Polyclonal Antibody
{{$productOrderCtrl.translations['antibody.pdp.commerceCard.promotion.promotions']}}
{{$productOrderCtrl.translations['antibody.pdp.commerceCard.promotion.viewpromo']}}
{{$productOrderCtrl.translations['antibody.pdp.commerceCard.promotion.promocode']}}: {{promo.promoCode}} {{promo.promoTitle}} {{promo.promoDescription}}. {{$productOrderCtrl.translations['antibody.pdp.commerceCard.promotion.learnmore']}}
产品信息
PA5-42860
种属反应
已发表种属
宿主/亚型
分类
类型
抗原
偶联物
形式
浓度
规格
纯化类型
保存液
内含物
保存条件
运输条件
RRID
产品详细信息
Peptide sequence: EDNEAPDSEE EDDEDGDEDD EEEEENEAGP PEGYEEEEEE EEEEDEDEDE
Sequence homology: Cow: 100%; Dog: 100%; Guinea Pig: 93%; Horse: 100%; Human: 100%; Mouse: 93%; Rabbit: 100%; Rat: 100%; Yeast: 82%; Zebrafish: 79%
靶标信息
Apoptosis is related to many diseases and development. Caspase-9 plays a central role in cell death induced by a variety of apoptosis activators. Cytochrome c, after released from mitochondria, binds to Apaf-1, which forms an apoptosome that in turn binds to and activate procaspase-9. Activated caspase-9 cleaves and activates the effector caspases (caspase-3, -6 and -7), which are responsible for the proteolytic cleavage of many key proteins in apoptosis. The tumor suppressor putative HLA-DR-associated proteins (PHAPs) were recently identified as important regulators of mitochondrion apoptosis. PHAP appears to facilitate apoptosome-medicated caspase-9 activation and to stimulate the mitochondrial apoptotic pathway. PHAP was also shown to oppose both Ras- and Myc-medicated cell transformation.
仅用于科研。不用于诊断过程。未经明确授权不得转售。
生物信息学
蛋白别名: acidic (leucine-rich) nuclear phosphoprotein 32 family, member A; Acidic leucine-rich nuclear phosphoprotein 32 family member A; Acidic nuclear phosphoprotein pp32; cerebellar leucine rich acidic nuclear protein; epididymis secretory sperm binding protein; hepatopoietin Cn; I1PP-2A; inhibitor-1 of protein phosphatase-2A; LANP; Leucine-rich acidic nuclear protein; Mapmodulin; PHAPI; Potent heat-stable protein phosphatase 2A inhibitor I1PP2A; pp32; Putative HLA-DR-associated protein I; putative human HLA class II associated protein I; RP4-790G17.1; unnamed protein product
基因别名: ANP32A; C15orf1; HPPCn; I1PP2A; LANP; MAPM; PHAP1; PHAPI; PP32
UniProt ID: (Human) P39687
Entrez Gene ID: (Human) 8125